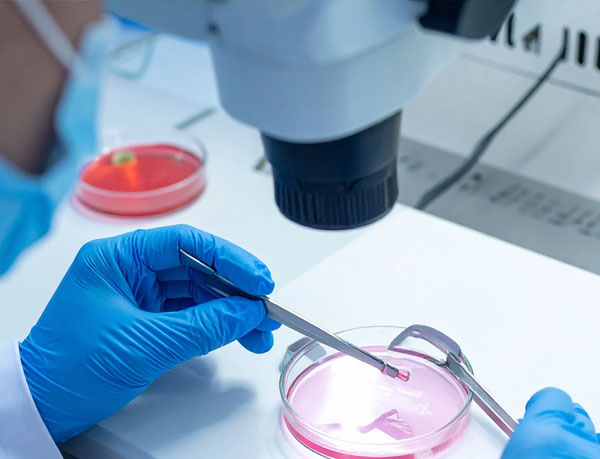

According to the World Health Organisation (2025), approximately 1 out of every 6 people experiences infertility during their reproductive age. This is where the role of In-Vitro Fertilisation (IVF) comes into play because it helps in satisfying contemporary demands, such as delayed parenthood. When couples experience difficulties in terms of conceiving, due to factors such as female infertility, male infertility, or unexplained infertility, then IVF increases the chances of achieving parenthood through timely and proper clinical intervention. Therefore, choosing the right fertility expert can help in this regard based on accurate diagnosis, ethical decision-making, and evidence-based practices.
Dr Shefali Bansal Madhav is widely regarded as the best IVF doctor in Siliguri due to her meticulous approach in terms of combining evidence-based approaches, advanced IVF techniques, and personalised treatment plans. As a highly-experienced IVF specialist, she prioritises detailed counselling, safe practices, and designing customised treatment planning so that the entire IVF process is transparent and ethical. Therefore, couples can receive IVF treatment with confidence and clarity over exaggerated beliefs.
Institute Of PGI, Chandigarh
In Siliguri, West Bengal
In Siliguri, West Bengal

Dr Shefali Bansal Madhav is one of the best IVF specialists in Siliguri due to her strong academic background in reproductive medicine and infertility, along with the implementation of a patient-centric approach. She has received extensive training in handling complex fertility cases from premier healthcare institutions, which enhances her clinical expertise.
Dr Shefali has several years of hands-on experience in procedures such as IVF, ISCI, IUI, Ovulation induction, and other forms of advanced assisted reproductive technology (ART). Over the years, she has delivered excellence in addressing female infertility, male infertility, unexplained infertility, and recurrent IVF failure. In addition, her ability to customise IVF treatment plans based on hormonal response, ovarian reserve, uterine receptivity, and sperm quality has helped in ensuring that the IVF treatment provided by her is safe, evidence-based, and ethical.
Apart from her clinical excellence, Dr Shefli Bansal Madhav is an active contributor in the field of medical academics. This is evident from her being a co-author in the chapters based on superovulation techniques and ovarian hyperstimulation syndrome. Some renowned ART textbooks have published her studies and research. Overall, her dedication to providing compassionate care, detailed counselling, and ethical planning makes her a top fertility specialist for couples seeking Infertility treatment in Siliguri.
Know MoreThe IVF treatment in Siliguri offered by Dr Shefali Bansal Madhav are designed as per individual fertility issues faced by couples that hinder the ability to naturally conceive. The first step of her IVF treatment planning involves a detailed fertility assessment and counselling so that the accurate reason for the fertility issue can be identified. Once the reason is identified and diagnosed accurately, she designs relevant treatment plans, such as ISCI, IUI, or IVF. In addition, she also offers supportive options, such as egg donation or fertility preservation, so that all potential needs of couples are addressed.
SOne of the major factors that drives the success of Dr Shefali Bansal Madhav is the use of advanced IVF techniques and a modern embryology laboratory. She prioritises offering modern fertility solutions, such as laser-assisted hatching, blastocyst culture, transvaginal ultrasound, and embryo selection. All these solutions prove to be immensely beneficial in terms of improving IVF success rates. Overall, the integration of ethical IVF practices and safe ART procedures ensures that patients receive complete fertility treatment tailored to address individual fertility issues.
Here are the fertility care services offered by Dr Bansal Madhav:
 In-Vitro Fertilisation (IVF)
In-Vitro Fertilisation (IVF) This is an advanced fertility treatment that involves fertilisation of an egg by a sperm in a lab dish so that an embryo can be created externally and then transferred into the uterus.
 Intrauterine Insemination (IUI)
Intrauterine Insemination (IUI) This fertility treatment is based on placing a concentrated and washed sperm directly into the uterus around ovulation. IUI is less invasive than IVF because it does not require egg retrieval.
 Intracytoplasmic sperm injection (ICSI)
Intracytoplasmic sperm injection (ICSI) ICSI is an advanced IVF technique where a single healthy sperm is directly injected into a single egg in a laboratory setting, so that the egg can be fertilised. This process helps in overcoming male infertility.
 Egg Donation
Egg Donation This is an ART where a fertile woman (donor) provides her egg to another woman who is unable to conceive due to fertility issues. The donor egg is fertilised in the laboratory, and then the embryo is transferred into the intended mother’s uterus.
 Recurrent Pregnancy Loss
Recurrent Pregnancy Loss This is a condition where a woman has suffered from two or more pregnancy losses due to underlying health conditions, anatomical issues, maternal issues, or genetic issues.
 Male infertility
Male infertility This is a condition where a man is unable to impregnate a fertile female partner after 12 months of regular and unprotected intercourse.
 Blastocyst culture
Blastocyst culture Blastocyst culture is an advanced IVF technique where embryos are grown in the lab for 5-6 days before being transferred into the uterus.
 Endometrial Receptivity Assay
Endometrial Receptivity Assay This is a genetic test done for IVF patients that helps in identifying the best time to transfer an embryo into the uterus.
 Laser Hatching
Laser Hatching This technique uses a highly-focused laser beam to create a small opening in the outer shell of an embryo that helps the embryo to hatch and implant easily into the uterus.
 Follicular monitoring
Follicular monitoring This monitoring technique is used to track the growth of follicles in the ovaries, which contain eggs. Thus, the exact time of ovulation can be determined through this monitoring technique.
 Transvaginal ultrasound
Transvaginal ultrasound This is based on using high-frequency sound waves through a slim probe being inserted into the vagina so that a detailed image of the vagina can be obtained.
Infertility can affect both men and women. According to WHO data, male infertility accounts for approximately 50% of global infertility cases. Thus, it is important to identify the root cause and underlying cause of infertility so that the most relevant treatment method can be used. Couples who are struggling to conceive due to lifestyle, hormonal, or clinical factors can benefit tremendously by seeking timely diagnosis and advanced treatment, such as IVF in Siliguri or a location of their convenience.
It has been observed that such advanced methods focus on offering personalised treatment, which in turn increases the chances of conception.

Female infertility is a condition where a female is unable to conceive after 12 months of regular and unprotected intercourse. If the female is above 35 years, then the timeline is 6 months. Various factors contribute to female infertility, which are as follows:

Male infertility refers to a condition where a male is unable to impregnate a female partner after more than 12 months of continuous and unprotected intercourse. The prevalence of male infertility reduces the chances of achieving a natural pregnancy. Some of the most common causes of male infertility are:
The IVF process is one of the most effective ways to overcome infertility because it involves fertilising an egg with sperm in a highly advanced laboratory. However, the process can be expensive and time-consuming, with the success rates being higher in young age. Thus, frozen embryo transfer is suggested during IVF in Siliguri if a woman wants a delayed pregnancy.
This process requires a systematic approach to ensure that stress and anxiety among patients can be removed. In addition, a systematic approach helps in increasing the success rates of IVF as well. Dr Shefali Bansal Madhav has earned massive praise due to her efficiency in offering a transparent and patient-centric approach based on the following steps:

As a top IVF specialist in Siliguri, Dr Shefali Bansal Madhav offers detailed and transparent consultation before starting the IVF treatment. This helps in ensuring that a customised treatment plan can be designed based on an analysis of individual medical history.

In this step, the female partner is administered doses of hormonal injections so that the ovary stimulates and produces multiple eggs. The hormonal injections can cause bloating and abdominal discomfort.

In this step, the mature egg is retrieved by giving anaesthesia. Once the egg is retrieved, it is mixed with sperm (either partner's or donor's sperm) in a lab dish. This is done to fertilise the egg so that it develops into an embryo.

After the egg is successfully fertilised, it is developed in a specialised laboratory setting so that an embryo is formed. As a part of practising advanced IVF in Siliguri, Dr Shefali Bansal Madhav uses blastocyst culture or other similar processes to select the healthiest embryo.
After selecting the healthiest embryo, it is transferred to the uterus of the female partner, which is done without any pain. Once successful embryo implantation is done, the pregnancy waiting period begins, which often requires specialised care through IVF.

After a wait of 12-15 days, a blood test is done to confirm pregnancy. The next steps are based on taking relevant measures depending on whether the pregnancy is successful or not. Dr Shefali Bansal Madhav prioritises using the beta hCG test for pregnancy analysis.
The concern related to IVF treatment expenses or cost is a major factor because IVF is generally expensive. However, IVF does not have a fixed price because it depends on individual health conditions and requirements. The average cost of a standard IVF cycle is around INR 100,000 to INR 200,000.
At a trusted IVF expert in Siliguri, such as Dr Shefali Bansal Madhav's clinic, a basic IVF package includes everything from initial consultation to egg fertilisation and embryo transfer. However, additional expenses might be required if an individual’s health condition requires additional interventions.
Here is an approximate breakdown of the average IVF cost:
| Treatment Component | Estimated Cost Range |
|---|---|
| Basic IVF Cycle | INR 100,000 - INR 200,000 |
| ISCI (requirement depends on situation) | INR 15,000 - INR 30,000 |
| Genetic testing | INR 40,000 - INR 60,000 |
| Embryo freezing | INR 20,000 - INR 30,000 |
| Frozen Embryo Transfer | INR 35,000 - INR 50,000 |
Please note that the above price breakdown is for estimation. The final cost can be determined after a detailed consultation.
The role of an IVF specialist is critical because it involves the use of complex reproductive medications through specialised skill, care, and judgment. IVF is not a “one-size-fits-all” procedure, which means comprehensive evaluations are required. Overall, your dream of achieving parenthood despite infertility issues can come true with this highly advanced procedure.
Choosing the best IVF specialist holds tremendous significance because it helps ensure that the chances of a successful IVF outcome become high based on high-level safety and precision. Dr Shefali Bansal Madhav is a leading name when it comes to choosing a highly qualified and experienced IVF doctor in Siliguri due to the following factors:

She is an MBBS and an MD in Obstetrics & Gynaecology. In addition, Dr Shefali has completed fellowship training in Reproductive Technology and Infertility from ICOG, FOGSI, Mumbai. Therefore, her academic background makes her a top choice to seek IVF treatment because such a qualification ensures the use of evidence-based practices and personalised care.
By choosing Dr Shefali Bansal Madhav, couples can receive detailed and transparent counselling, which helps in setting realistic expectations for IVF in Siliguri. Thus, you can make informed decisions without any uncertainty related to outcomes or cost due to ethical treatment guidance. Since IVF requires financial as well as emotional investment, an ethical approach plays a vital role.
Each IVF cycle offered by Dr Shefali Bansal Madhav is customised as per ovarian reserve, sperm quality, hormonal response, and other uterine factors. Therefore, the effectiveness of the treatment plan increases based on a personalised approach. This approach reflects a patient-centric approach followed by her as part of IVF treatment.
She offers infertility care to both males and females if it is required under a single IVF treatment plan, which ensures comprehensive treatment. Conditions, such as PCOS, low-sperm motility, and endometriosis, are addressed in isolation so that confidentiality is maintained.
She has an excellent track record in terms of handling complex cases, including previously failed IVF attempts. Her practice is deeply rooted in the belief that patient outcomes speak louder than promotions. This makes Dr Shefali Bansal Madhav a reliable IVF doctor in Siliguri for seeking effective and clinically sound fertility care.
By going through these insight videos of Dr Shefali Bansal Madhav, you can gain significant insights into various fertility topics. As a top IVF specialist in Siliguri, Dr Shefali Bansal Madhav firmly believes that it is her ethical and moral responsibility to educate people about infertility and IVF procedures so that people can make informed decisions.
Here is what the clients of Dr Bansal Madhav have to say about her:
An extraordinary fertility expert….Will definitely recommend to everyone without any hesitation. Have a very good time in Dr. Bansal’s clinic.

Bishal Das
Siliguri
Everyone in her clinic was very good. They truly cared about us and fulfilled all our requirements. Dealing with fertility issues are stressful but with Dr. Bansal’s help everything was sorted.

Geetanjali Ghosh
Siliguri
Dr. Shefali Bansal Madhav was very kind and compassionate during my whole fertility journey. Thank you ma’am for your support and guidance.

Rohini Misra
Jalpaiguri
Dr. Shefali Bansal Madhav is fantastic…She gifted me the dream which I have dreamt for so many years. I am forever indebted to you.

Prakash Bunia
Darjeeling
Dr. Bansal was so understanding and friendly during the entire process. This helped a lot to forget all my tension and anxiety regarding the treatment

Neha Singh
Kalimpong
I am husband of subhra biswas. life is not easy when you are not having a baby after years being married. then there was dr. shefali bansal madhav. who didnt just treat our issues also understand the issues and anxiety of us. thanks to dr. for whom we are going to be a proud parent.

Mahimoy Biswas
Siliguri
Multiple rounds full of anxiety stress…but ended with joy and comfort…. All thanks to Dr. Shefali Bansal Madhav.

Madhavi Roy
Siliguri
Yes, young women can experience infertility due to conditions such as blocked fallopian tubes, endometriosis, PCOS, hormonal imbalance, or genetic factors, even in their 20s or early 30s. However, early diagnosis and proper clinical intervention can resolve such infertility issues in young women.
The approach of Dr Shefali Bansal Madhav is highly patient-centric in terms of offering the best IVF treatment in Siliguri. Over the years, she has earned a tremendous reputation for delivering successful outcomes in IVF through her in-depth knowledge, experience, and evidence-based practices.
IF is generally not painful because of the use of advanced techniques. However, the stages of administering hormonal injections and egg retrieval might involve mild-to-moderate pain or discomfort, which goes away within a few days.
The success rate of IVF at Newlife Fertility Centre, where Dr Shefali Bansal Madhav is affiliated with, is high due to the use of advanced technologies and high-level clinical expertise. However, one must consider the factors of age and overall health condition as well because they play a vital role in determining IVF success.
The average timeline of one full IVF cycle is around 4-6 weeks. The stages involved in this timeline are egg stimulation, egg retrieval, egg fertilisation, blastocyst culture, and embryo transfer. However, the timeline can extend further depending on age and health factors.
Women generally experience mild-to-moderate pain and discomfort during the administration of hormonal injections and egg retrieval. The pain is not severe and is usually manageable with rest and medications.
No form of reproductive treatment can guarantee pregnancy. IVF is a highly advanced form of reproductive treatment, which significantly increases the chance of pregnancy. However, the aspect of a successful pregnancy relies on age and health condition.
To choose the right IVF doctor in Siliguri, you need to consider checking for relevant qualifications, experience, and success rates. One of the most important things is not to compromise on quality by prioritising low-cost IVF treatment. In addition, you can ask for the success rate based on your individual fertility issue. A reliable IVF doctor, such as Dr Shefali Bansal Madhav, will provide you with transparent details of such information.
The process of IVF treatment has been developed to help women aged 35 and above to achieve pregnancy. However, the chances of IVF success reduce after the age of 40 due to reduced ovarian reserve and poor egg quality. Thus, it is advised to seek IVF assistance before the age of 40 so that the chances of success remain high.
There are no direct side effects of IVF. However, women can experience mild pain, bloating, cramps, and mood swings due to the administration of hormonal injections. In addition, a top IVF doctor carefully monitors the situation, which reduces the chances of potential side effects.
Several couples have achieved a successful pregnancy on the first cycle. However, women aged 35 and above or with underlying health conditions might require 3-4 attempts. Please note that the success rate of IVF comes down after the third attempt.
Yes, IVF is widely regarded as a safe procedure for both mother and baby when it is performed by a certified and experienced IVF specialist. Babies born through IVF are just as healthy as those born through natural conception.
Ye, IVF proves to be highly effective for addressing male infertility, especially when combined with Intracytoplasmic Sperm Injection (ICSI). This is because ICSI involves the process of injecting a single healthy sperm directly into an egg.
Yes, positive lifestyle changes play a vital role in terms of improving the success rates of IVF. According to clinical research and studies, a healthy lifestyle improves hormonal balance, sperm quality, egg quality, and implantation rates. Therefore, a healthy diet and moderate exercise need to be prioritised.
The premier IVF centres in this city report more than 60% success rate in IVF based on the use of additional procedures, such as ICSI and IUI. The reason behind the high success rates of premier IVF centres is the use of high-level clinical expertise, a personalised approach, and modern technologies.
Yes, IVF in Siliguri offers financing options with 0% interest to make it convenient for couples to achieve the dream of parenthood. The growing number of infertility cases in all sections of the population has made it mandatory to make IVF treatment convenient for all.